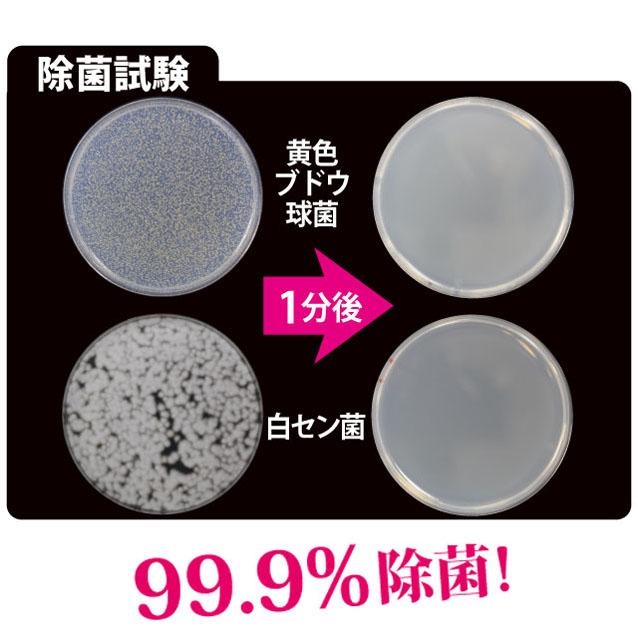
除菌スプレー

99.9%除菌【NADESHIA】除菌・抗菌スプレー 80ml アルコール 除菌 抗菌 消毒 天然成分 高濃度 アルコール除菌スプレー<メール便不可>(リヨンプランニング NA-21)
968円(税込)
0ポイント(1%)
配送情報
お届け予定日:12月12日〜12月17日
※一部地域・離島につきましては、表示のお届け予定日期間内にお届けできない場合があります。補足事項
一度に3個まで購入可能
ロットナンバー
442441764
商品説明

☆洗浄後、乾くまでの間のカビや菌の繁殖予防に
・対象物の水気をきった後に、表面や内側に数回スプレーし、陰干しする。
☆メイクブラシのちょこっと洗浄に(1週間に1回ほど)
・小さいブラシ:ティッシュに2、3回スプレーし湿らせ、拭き取り、自然乾燥。
・大きいブラシ:ブラシに直接2、3回スプレーし、ティッシュで拭き取り、自然乾燥。
※汚れがひどい場合はこの製品ではなく、中性洗剤等でしっかり汚れを洗い流す。
☆とりあえず除菌
・対象物の全体に軽く1、2回スプレーし、自然乾燥。(液のかけ過ぎに注意)
【使用上の注意】
●用途以外に使用しない。
●対象物を直接、液に浸さない。
●引火の恐れがあるので火気付近で使用しない。
●換気に注意する。
●塩素系漂白剤・洗浄剤と混ざると有害なガスが発生する恐れがあるので注意する。
●直射日光をさけ、高温や火気の近くに置かない。
●ご使用後はキャップをしっかりと閉めて保管してください。
●小さいお子様の手の届かない所へ保管してください。
メイクブラシ、お手入れしていますか?
除菌・抗菌スプレー (JAN:4560130658152)
— NADESHIA ナデシア—
シリーズ展開の除菌・抗菌スプレー。
高濃度アルコールでしっかり除菌。
グレープフルーツ種子エキス配合で除菌効果も長持ち。
食品に使える100%天然成分配合なので安心。
洗浄後、乾くまでの間のカビや菌の繁殖予防に。洗いたい!でも洗えない時に...。
メイクブラシのちょこっと洗浄に(1週間に1回ほど)
とりあえず除菌に。
パサつき防止としてシルクプロテイン【セリシン】配合。
時短&いつでも清潔の為のスプレー。
日本製
販売業者:株式会社リヨンプランニング
所在地:〒577-0067 大阪府東大阪市高井田西2-3-21-101
除菌・抗菌スプレー (JAN:4560130658152)
— NADESHIA ナデシア—
シリーズ展開の除菌・抗菌スプレー。
高濃度アルコールでしっかり除菌。
グレープフルーツ種子エキス配合で除菌効果も長持ち。
食品に使える100%天然成分配合なので安心。
洗浄後、乾くまでの間のカビや菌の繁殖予防に。洗いたい!でも洗えない時に...。
メイクブラシのちょこっと洗浄に(1週間に1回ほど)
とりあえず除菌に。
パサつき防止としてシルクプロテイン【セリシン】配合。
時短&いつでも清潔の為のスプレー。
日本製
販売業者:株式会社リヨンプランニング
所在地:〒577-0067 大阪府東大阪市高井田西2-3-21-101
成分
エタノール、水、プレープフルーツ種子エキス、セリシン
※セリシン=シルクプロテイン
【原産国】日本
※セリシン=シルクプロテイン
【原産国】日本
レビュー
商品の評価:



 -点(0件)
-点(0件)
お店の情報
お店の評価:



 -点(0件)
-点(0件)
連絡・応対
-
配送スピード
-
梱包
-









